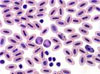

| Сайт для врачей и фармацевтов | |||||||||||||||||||||||||||||||||||||||||||||||||||||||||||||||||||||||||||||||||||||||
|
| ||||||||||||||||||||||||||||||||||||||||||||||||||||||||||||||||||||||||||||||||||||||
| Партнеры | Vox populi - vox dei |
Результаты предыдущих голосований В каком виде Вы предпочитаете читать книги по медицине? Только бумажные издания - 35 [12%]   Предпочитаю бумажные, но согласен и в электронном виде - 94 [33%]   Мне все-равно электронные или бумажные, лишь бы полезные - 101 [36%]   Предпочитаю электронные, потому, что они дешевле бумажных аналогов - 51 [18%]   Всего голосов: 282 | |
| Главная Болезни Синдромы Диагностика Лечение Образование Сотрудничество Подписка PR Зарубежье | |||
|
Medicus Amicus - это медицинский сайт, фотосайт, психологический сайт, сайт постоянного медицинского образования, медицинская газета и даже медицинский журнал. Все замечания и пожелания присылайте используя форму обратной связи Все права защищены и охраняются законом. © 2002 - 2026 Rights Management Автоматизированное извлечение информации сайта запрещено. Подробности об использовании информации, представленной на сайте в разделе "Правила использования информации" | |||
|
| |||





 Оптимальное лечение гормонально-чувствительного рака молочной железы (РМЖ) у женщин в пременопаузе до сих пор служит предметом дебатов среди специалистов. Доля таких больных..
Оптимальное лечение гормонально-чувствительного рака молочной железы (РМЖ) у женщин в пременопаузе до сих пор служит предметом дебатов среди специалистов. Доля таких больных.. Валериана лекарственная - многолетнее травянистое растение из семейства валериановых. Корневище короткое, вертикальное, толстое, внутри полое с многочисленными корнями. Стебель пря..
Валериана лекарственная - многолетнее травянистое растение из семейства валериановых. Корневище короткое, вертикальное, толстое, внутри полое с многочисленными корнями. Стебель пря.. Новый антиретровирусный препарат маравирок (maraviroc, Celsentri/Selzentry; Pfizer) является антагонистом хемокинового рецептора CCR5. Рецептор CCR5 клетки-мишени необходим для свя..
Новый антиретровирусный препарат маравирок (maraviroc, Celsentri/Selzentry; Pfizer) является антагонистом хемокинового рецептора CCR5. Рецептор CCR5 клетки-мишени необходим для свя.. антитромбоцитарной терапии (ДАТ) после имплантации СВЛ, а также соотношение риска и..
антитромбоцитарной терапии (ДАТ) после имплантации СВЛ, а также соотношение риска и.. глиобластомы высокой степени злокачественности (анапластическая, мультиформная), анапластическая астроцитома и олигодендроглиома, эпендимальные опухоли, медуллобластома и др. прими..
глиобластомы высокой степени злокачественности (анапластическая, мультиформная), анапластическая астроцитома и олигодендроглиома, эпендимальные опухоли, медуллобластома и др. прими..
 Новости
Новости 